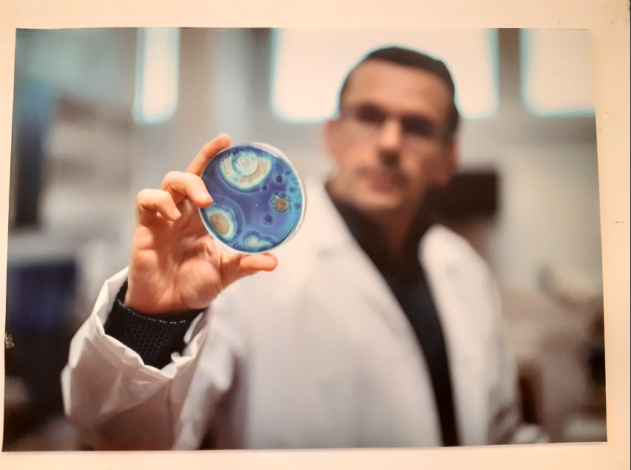

Titkos egyetemi helyiségek, kutatók, a nagyközönség előtt elzárt laborjai tárulnak fel a szemünk előtt – megnyílt az SZTE sajtófotó kiállítása az Agórában

“Titkos” egyetemi helyiségek, kutatók, tudósok a nagyközönség előtt elzárt laborjai, műhelyei tárulnak fel a szemünk előtt a Szegedi Tudományegyetem fotóriportereinek kedden a Szent-Györgyi Albert Agóra aulájában nyílt kiállításán, melyet egészen január 31-ig tekinthetünk meg.
Új helyszínen, a Szent-Györgyi Albert Agórában láthatóak újra a szegedi egyetem fotóriportereinek fényképei. A tárlat során “titkos” egyetemi helyiségek, kutatók, tudósok a nagyközönség előtt elzárt laborjai, műhelyei tárulnak fel a szemünk előtt az SZTE Nemzetközi és Közkapcsolati Igazgatóság kollégáinak -Bobkó Anna, Molnár Dóra, Kovács-Jerney Ádám és Sahin-Tóth István- objektívjén keresztül. Olyan helyek, ahova az átlagemberek csak a Kutatók Éjszakáján nyerhetnek betekintést, az egyetem újságírói és fotósai viszont hétköznapi vendégek.
AGYMŰTÉTTŐL A GÓLYAESKÜIG
Mint a kiállítás ünnepélyes keddi megnyitóján Prof. Dr. Széll Márta, az SZTE stratégiai rektorhelyettese elmondta, az agyműtéttől a gólyaesküig, a labormunkától a sportig terjed a fotók témája. A kiállítás látogatói “találkozhatnak” a Nobel-díjas Karikó Katalinnal, oktatókkal, hallgatókkal, az egyetemi közösség tagjaival. A tárlat különlegessége, hogy a képaláírásokhoz tartozó QR-kódokon keresztül elolvashatják az adott fotóhoz kapcsolódó újságcikket is.
A rektorhelyettes arra is felhívta a figyelmet, a megnyitó nem véletlenül esett a mai napra, Karikó Katalin születésnapjára. Az SZTE fotótárlata ugyanis része a “Nobel-hetek a Szegedi Tudományegyetemen” ismeretterjesztő kampánynak.
MINÉL JOBBAN ELKAPNI A PILLANATOT
Mint Bobkó Anna, az egyik kiállító elmondta, őt leginkább az inspirálja képei elkészítésénél, hogy minél jobban elkapja a pillanatot, és megőrizzék azt az utókor számára. Egy egyszerű fotónál azonban meglátása szerint valamennyien az SZTE fotósai közül többet szeretnének nyújtani. “Arra törekszünk, hogy legyen művészeti értéke is a képeknek, hogy mindig egy kis csavarral fotózzuk le azt, amit a másik ember is lát, úgy, hogy a néző számára az érdekes legyen” – mondta el Anna. Hozzátette az IKIKK, azaz a Szegedi Tudományegyetem Interdiszciplináris Kutatásfejlesztési és Innovációs Kiválósági Központja PR referenseként elsősorban kutatókról készíti képeit.
“VOLTAM MÁR AGYMŰTÉTEN IS FOTÓZNI”
“Nagyon szeretek laborokba bemenni, olyan helyekre, ahová az átlagember nem juthat be. Voltam már agyműtéten, ahol az operáció közben magyarázta nekem az orvos, hogy mi történik, az nagyon izgalmas volt. Az ELI-ALPS Lézeres Kutatóintézet olyan részeiben, amelyeket egyébként még a Kutatók Éjszakáján sem nyitnak meg a közönség előtt, én ott is fotózhattam. A személyes kedvencem a képeim közül, amelyeket az egyetem archeogenetikai kutatásaival kapcsolatban készítettem, például a koponyás kép” – árulta el Bobkó Anna.

“KIUGRASZTANI A NYUSZIT A BOKORBÓL”
Kovács-Jerney Ádám úgy fogalmazott, számára minden kép készítésénél egy nagy kihívás, hogy úgymond “kiugrassza a nyuszit a bokorból”, bemutassa azt, hogy minden egyes kép mögött egy hús-vér ember lakozik. “Mindig az őszinteséget próbálom keresni mindenhol, számomra az az igazán izgalmas. A kedvenc helyszínem a fotózáshoz az ELI, ahol olyan helyeken, olyan területeken járhattam, hogy nem is gondoltam, hogy ilyenek vannak a hatalmas komplexumban. Számomra ez nagyon-nagyon izgalmas” – avatott be bennünket Ádám.
KARIKÓ KATALINNAL A NOBEL-DÍJ ÁTADÓJÁRA
Sahin-Tóth István, mint kiemelte különleges munkát végez az egyetemen. Ő fotózza ugyanis Nobel-díjas kutatónkat, Karikó Katalint. A professzort például elkísérte Stockholmba, a hatalmas presztízzsel bíró elismerés átadó ünnepségére is. “Alapvetően már több éve dolgozom együtt Karikó Katalinnal. Ez az évek alatt kicsit átalakult baráti kapcsolattá. Ami nagyon megfogott a kutatóprofesszorban, hogy Karikó Katalin mennyire őszinte, ő sosem akart magából többet mutatni, mint aki. Amit kifejezetten kiemelnék a legutóbbi utunk volt Stockholmba, a Nobel-díj átadóra. Hatalmas élmény volt számomra fotósként részt venni az eseményen” – mesélte el István.
Hozzátette, a kedvenc képe, amikor Krausz Ferencet és Karikó Katalint a stockholmi magyar nagykövetségen köszöntötték, ők pedig megfogták egymás kezét és a magasba nyújtották, miközben mindenki tapsolt és hangosan ünnepelte őket. “Hatalmas pillanat volt, amin ott lehettem, s tényleg szívet melengető volt, ahogy megölelték egymást és tényleg mindenki őket ünnepelte” – zárta gondolatait Sahin-Tóth István.

A „Sajtófotók a Szegedi Tudományegyetemről” című tárlat 2024. január 31-ig látogatható, kísérő programként megtekinthető az Agórában az SZTE gondozásában rendezett informatikatörténeti kiállítás is.
Fotók: az Agórában megtekinthető SZTE sajtófotó kiállítás anyagából származnak